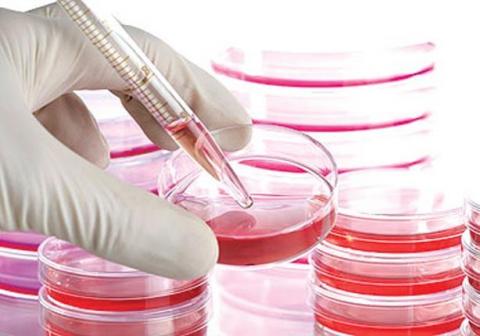

أعلنت الإمارات عن ابتكار علاج لفيروس "كورونا المستجد" بـ"الخلايا الجذعية".
وقالت وكالة أنباء الإمارات اليوم الجمعة إن وزارة الاقتصاد منحت براءة اختراع لعلاجٍ بـ"الخلايا الجذعية" مبتكر وواعد لالتهابات فيروس "كورونا المستجد"، وقد طور هذا العلاج فريق من الأطباء والباحثين في مركز أبوظبي لـ"الخلايا الجذعية" ويتضمن استخراج "الخلايا الجذعية" من دم المريض وإعادة إدخالها بعد تنشيطها.
ومنحت براءة الاختراع للطريقة المبتكرة التي يتم فيها جمع "الخلايا الجذعية".
وتمت تجربة العلاج في الدولة على 73 حالة وشفيت، وظهرت نتيجة الفحص سلبية بعد إدخال العلاج إلى الرئتين من خلال استنشاقه بواسطة رذاذ ناعم. ومن المفترض أن يكون تأثيره العلاجي عن طريق تجديد خلايا الرئة وتعديل استجابتها المناعية لمنعها من المبالغة في رد الفعل على عدوى "كورونا" والتسبب في إلحاق الضرر بالمزيد من الخلايا السليمة.
وقد خضع العلاج للمرحلة الأولى من التجارب السريرية واجتازها بنجاح، ما يدل على سلامته. ولم يبلغ أي من المرضى الذين تلقوا العلاج عن أي آثار جانبية فورية، ولم يتم العثور على أي تفاعلات مع بروتوكولات العلاج التقليدية لمرضى "كورونا" وتستمر التجارب؛ لإثبات فعالية العلاج ومن المتوقع أن تستكمل في غضون أسبوعين.
تجدر الإشارة إلى أنه تم تقديم العلاج للمرضى تزامنًا مع التدخل الطبي التقليدي، وسيستمر تطبيقه مساعدًا لبروتوكولات العلاج المعمول بها وليس بديلاً لها.
(د ب أ):

.jpg)
.jpg)
.gif)



.jpg)
